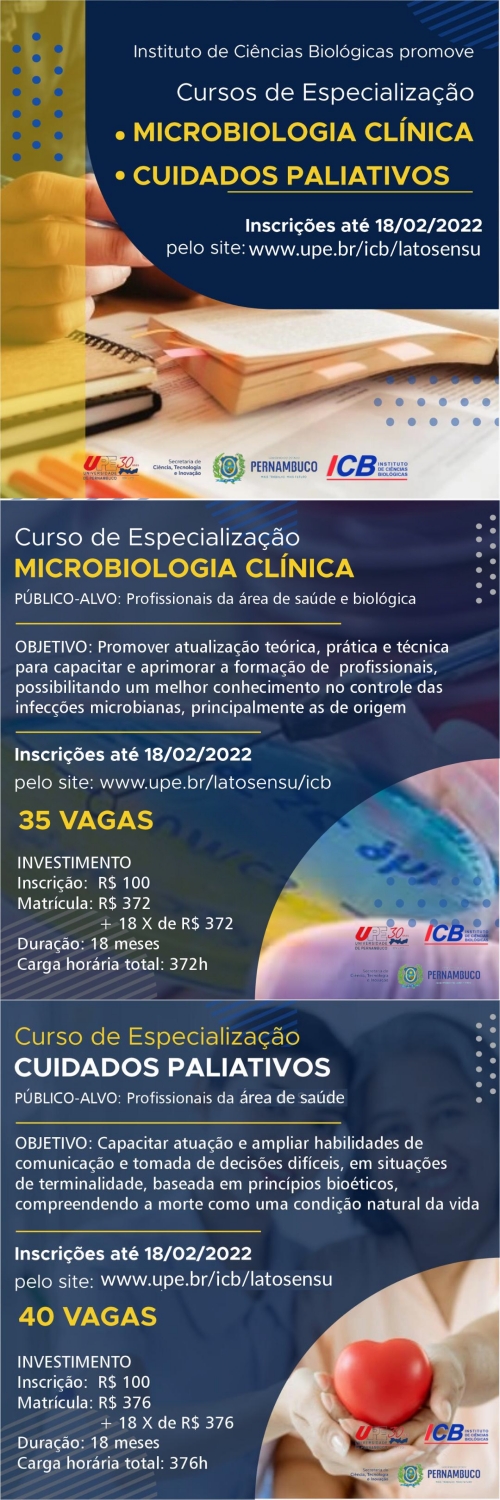

Realizado pela Universidade de Pernambuco nos seus campi Caruaru, Garanhuns e Arcoverde (Lócus Inovatel e Lócus Garanhuns Smart City) e patrocinado pela Superintendência de Desenvolvimento do Nordeste (Sudene), o TechDay UPE acontecerá nos dias 28, 29 e 30 de setembro.
O evento tem como objetivo fazer uma discussão temática sobre as tendências de soluções com base tecnológica, buscando disseminar conhecimentos de forma interdisciplinar/multidisciplinar. A meta é promover tecnologias habilitadoras com foco especial em Computação em Nuvem.
O TechDay UPE, que é realizado desde 2018, é composto por palestras que irão abordar temáticas emergentes e tecnologias habilitadoras.
Além disso, haverá minicursos e o Momento Startup, que consiste no incentivo ao empreendedorismo inovador que incorpore novas tecnologias aos setores econômicos estratégicos da cidade de Garanhuns.
PROGRAMAÇÃO:
28/09/2021
15h às 16h: Palestra sobre Governo Digital
16h às 17h: Impulsionando negócios com soluções inteligentes
Minicurso: Desenvolvimento em Nest.JS - 19h às 21h
29/09/2021
14h: Momento Startup - Como usar tecnologias habilitadoras para ajudar a região do Agreste?
30/09/2021
15h às 16h: Cultura Startup: Empreendedorismo e inovação no centro dos negócios
16h às 17h: Desmistificando DevOps: Projetando Arquiteturas Efetivamente Escaláveis
Minicurso: Migração e armazenamento de dados na Nuvem - 19h às 21h
INSCRIÇÕES:
Link para inscrições no Ciclo de Palestras: https://www.sympla.com.br/techday-upe-setembro-2021__1348924
Link para inscrições no Concurso Momento Startup: https://forms.gle/cB2BVD9FXS1QkPFh8

Na manhã desta terça-feira (21), foi realizada uma cerimônia de colação virtual de 40 concluintes do curso de licenciatura em Ciências Biológicas na modalidade de ensino a distância (EAD) da Universidade de Pernambuco.
Na manhã desta terça-feira (21), foi realizada uma cerimônia de colação virtual de 40 concluintes do curso de licenciatura em Ciências Biológicas na modalidade de ensino a distância (EAD) da Universidade de Pernambuco.